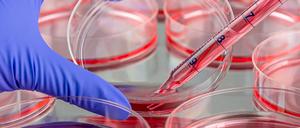

Themen, Tipps, Termine - nicht nur zu Weihnachten - in unseren Bezirksnewslettern, dienstags aus Tempelhof-Schöneberg, Spandau und Marzahn-Hellersdorf. Eine Vorschau.

Themen, Tipps, Termine - nicht nur zu Weihnachten - in unseren Bezirksnewslettern, dienstags aus Tempelhof-Schöneberg, Spandau und Marzahn-Hellersdorf. Eine Vorschau.

Ein freundlicher Mensch war er und ein freundlicher Chef. Als er selbst einen Chef bekam, der ganz anders war als er, wurde es schwierig

In einem Forschungsprojekt untersucht ein Historikerteam das Phänomen der Hochstapelei – besonders am Beispiel von Harry Domela.

Er war Künstler, er lebte von der Kunst. Sei es am Theater, sei es vor Dieter Bohlen

Der Präsident der Freien Universität Berlin über die Aufgaben der Hochschule anlässlich des Jubiläumsjahrs.

Schwarz-Rot will eine Unibibliothek rund um die Uhr öffnen. Eine Hochschule lehnt das bereits ab, die anderen sind prinzipiell aufgeschlossener.

Mit Abendessen oder Schwarzlichtminigolf feiern Berliner Unternehmen das ablaufende Jahr mit ihrer Belegschaft. Ein Experte erklärt, wie die Weihnachtsfeier gelingt.

„Menschliche Schutzschilde“ sind eine besonders perfide Kriegswaffe. Auch die Hamas setzt sie in Gaza ein. Doch wie steht es um die völkerrechtliche Bewertung?

Mehr als 2100 Wissenschaftlerinnen und Wissenschaftler haben einen offenen Brief gegen judenfeindliche Anfeindungen im Land unterzeichnet. Die Initiatoren kritisieren auch die Verdrehung von Tatsachen im Nahostkonflikt.

Auch für mehr Polnischunterricht an Brandenburger Schulen spricht sich die Landtagsabgeordnete Sahra Damus aus. Das könnte manchmal wichtiger sein als Französisch oder Spanisch.

Die Verteilung der Ministerien in Polen steht, die neue Regierung unter Donald Tusk möchte bald loslegen. Experten erklären, was Deutschland und Europa vom neuen Team erwarten dürfen.

Als neue Herausgeberin der Anderen Bibliothek führt Julia Franck die Andere Bibliothek mit einem einzigartigen Exilroman fort.

Der ukrainische Autor, DJ und Musiker Yuriy Gurzhy lebt seit 1995 in Berlin. Hier schreibt er über den Krieg in der Ukraine.

Monika Schnitzer ist die Chefin der Wirtschaftsweisen. Im Interview erklärt sie, wo die Regierung sparen kann – und wie die Schuldenbremse reformiert werden muss.

Fachkräftemangel und wirtschaftspolitische Unsicherheiten lähmen offenbar den Erfindergeist in der deutschen Wirtschaft. Einer DIHK-Umfrage zufolge ist die Innovationsbereitschaft von Firmen deutlich gesunken.

Auch nach drei Wochen Haushaltschaos ist unsicher, wie die Modernisierung des Landes gelingen soll. Für Zehntausende geht es um die wirtschaftliche Existenz. Ein Report aus einem Land in Angst.

Drei Universitäten und die Charité forschen unter dem Label „exzellent“ und bekommen dafür Millionen Bundesmittel. Viele halten Berlin für das Zentrum der deutschen Wissenschaft. Zu Recht?

ICE-Werk, Science Park, Energiewende: Für den Strukturwandel fließen Milliarden in die brandenburgische Lausitz. Langsam wird die Transformation sichtbar, doch fehlen Fachkräfte. Ein Besuch im Cottbuser Revier.

Am Freitag hat das Oberlinhaus einen neuen Standort in Potsdam-Babelsberg offiziell eröffnet. Schule, Werkstätten und andere Angebote werden hier unter einem Dach vereint.

Die neuen Forschungsergebnisse zu dem erfolgreichen deutschen Bildhauer wurden am Samstagabend im Westend vorgestellt – erfreulich unaufgeregt und vor vollem Haus.

Mit Weihnachtsmärkten, goldenen Sammlerstücken und einer abenteuerlichen U-Bahn-Fahrt schlittert Berlin in die Adventszeit. Rätseln Sie sich in zehn Fragen durch die Woche!

Das Ozonloch im Winter über dem Südpol war nach der Reduktion der schädlichen FCKW stetig kleiner geworden. Nun scheint sich diese Entwicklung aber zu verlangsamen.

Santos wird unter anderem wegen Betrugs und Identitätsdiebstahls angeklagt. Am Freitag stimmte eine Zweidrittelmehrheit von Republikanern und Demokraten für seinen Rauswurf.

Viele Menschen leiden derzeit in Deutschland an Atemwegserkrankungen. Woran das liegt, warum das Gerede vom „untrainierten Immunsystem“ ein Mythos ist und wie man sich schützt.

Nachdem aus Gaza erneut Raketen fliegen, nimmt Israel den Kampf gegen die Islamisten wieder auf und wird wohl in den Süden vorrücken. Wie die nächsten Tage und Wochen aussehen könnten.

Aktivisten von „Scientist Rebellion“ fordern den Abbau von klimaschädlichen Subventionen. Bei einer Protestaktion zogen sie zu den Berliner Büros der Firma Wintershall Dea.

Am 2. Dezember veranstaltet der Senat eine Dankesfeier für Engagierte – doch die Benefits gibt es vorrangig nur mit Ehrenamtskarte. Die 200 Stunden ehrenamtliche Arbeit könnten noch nicht mal Rentner nachweisen.

Unter Audiophilen genießt das Berliner Unternehmen einen Ruf wie Donnerhall. Doch vor einigen Jahren wäre fast alles vorbei gewesen. Ein Werkstattbesuch.

Wie geht es nach dem Ende der Waffenruhe mit den verbliebenen Geiseln im Gazastreifen weiter? Zwei Experten sind skeptisch, was künftige Verhandlungen angeht.

Am Anfang himmelt Viktor Mel an, weil sie älter ist und in der Feierszene alle kennt. Aber irgendwann hält er ihren Lifestyle nicht mehr aus.

Dem Islamwissenschaftler Michael Kiefer zufolge hat sich die Gefährdungslage seit dem 7. Oktober deutlich erhöht. Dass Tschetschenen in Anschlagspläne involviert sind, sei nicht ungewöhnlich.

In Großbritannien zeigten sich nach einem solchen Projekt viele Unternehmen interessiert an einer Einführung. Nun soll die Vier-Tage-Woche auch in Deutschland getestet werden.

Aus Sicht der Staatsanwaltschaft ist der Anfangsverdacht der Unterschlagung erfüllt. Zunächst geht es um rund 4400 Schuss verschwundener Munition für Sportschützen bei der Polizei.

Eine Liste im Netz brandmarkt Kultureinrichtungen, die angeblich zu israelfreundlich seien. Nach ihrem Bekanntwerden haben die Macher jetzt Konsequenzen gezogen.

Nach dem Karlsruher Urteil fehlen der Regierung 60 Milliarden Euro, um die Klimawende zu stemmen. Woher das Geld kommen soll und ob Klimaschutz immer so teuer ist, verrät Ökonom Andreas Löschel.

An den Unis ist das Führungspersonal aus Ostdeutschland immer noch unterrepräsentiert – wie kam es dazu? Ob sich daran bald etwas ändern wird, ist noch unklar.

Sterbehilfe, Schwarzfahren, Schadensmeldung nach Unfall: Was dazu im Strafgesetzbuch steht, wirkt heute überholt. Marco Buschmann plant eine Modernisierung.

Handelsexperten glauben nicht, dass Investoren derzeit Interesse haben könnten an der Warenhauskette Galeria Karstadt Kaufhof. Dafür sei die Markt- und Zinslage zu düster.
Die Arbeitsgruppe Gentechnologiebericht ist an die Charité umgezogen, nun erscheint ein Themenband zu Gen- und Zelltherapie. Hat die Unabhängigkeit des Gremiums unter dem Umzug gelitten?

Nicht-binäre und trans Personen, die als Beamte für den Bund tätig sind, sollen künftig mehr Möglichkeiten bei der Wahl der Amtsbezeichnung haben. Doch den Genderstern will das Innenministerium nicht zulassen.
öffnet in neuem Tab oder Fenster